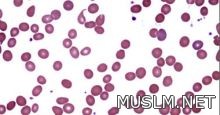

|
|
يعتبر الحديد من أهم المعادن والعناصر الغذائية اللازمة للجسم، فهو يدخل فى تركيب الهيموجلوبين الذى يتم بواسطته نقل الأكسجين من الرئة إلى الخلايا والأنسجة.
ويقول د. حسام عبد الغفار استشارى التغذية العلاجية إنه من فوائد الحديد الهامة أنه يقوى جهاز المناعة ويرفع قدرة الجسم على مقاومة الأمراض، كما أنه يدخل فى تركيب الهيموجلوبين الذى يخزن الأكسجين لاستخدامه فى انقباض العضلات.
وعن المصادر الغذائية للحديد فيوجد فى الفواكه كالتفاح والمشمش والخوخ وفى الخضراوات كالخس والخرشوف والباذنجان والبقدونس وفى اللحوم الحمراء والكبدة وصفار البيض أيضا.
وبالنسبة لأضرار نقص الحديد فى الجسم فإنه يسبب العديد من المشكلات أهمها الإصابة بالأنيميا (فقر الدم) وخاصة عند السيدات عند حدوث نزيف نتيجة نزول الدورة الشهرية بغزارة، وكذلك فى حالات الولادة تفقد المرأة الكثير من الدماء التى تحتوى على نسبة عالية من الحديد، كما يتسبب نقص الحديد أيضا إلى جفاف البشرة وضيق للتنفس، وإحساس بالتعب وعند الأطفال يؤدى لفقدان الشهية وتأخر النمو العقلى.
|
|
|
|
|
0 |
0 |
957


